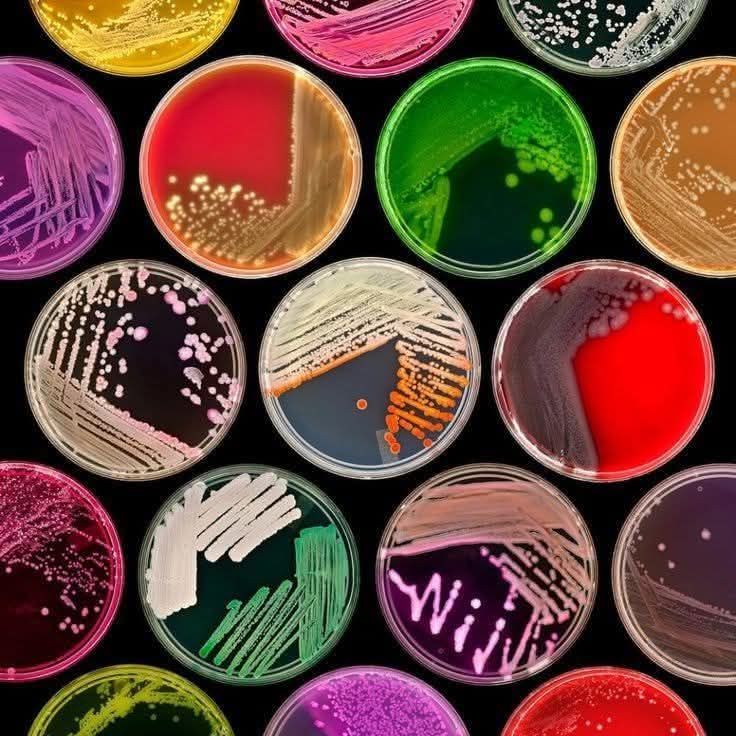

Información del curso
Para una mejor comprensión de la Microbiología es necesario el conocimiento de la Ecología, Biología y Bioquímica, mismas que servirán de base en el caso de Ingeniería ambiental para Toxicología y otras asignaturas posteriores que consideran los diferentes planes de estudio.
La Microbiología ha dependido del desarrollo de algunas herramientas, principalmente el microscopio, técnicas de esterilización, preparación de medios de cultivo, métodos de obtención de cultivos puros y de conservación de cepas. Con esta materia el estudiante adquiere habilidades que obtendrá en el laboratorio, a través de una serie de prácticas desarrolladas de acuerdo al conocimiento teórico adquirido.
Por tanto la asignatura aporta al perfil del Ingeniero en Industrias Alimentarias la capacidad de seleccionar, adaptar y modificar equipos y procesos en los que se aprovechen de manera sustentable los recursos bióticos, identificar y aplicar tecnologías emergentes relacionadas con el campo de acción de las ingenierías, participar en el diseño y aplicación de normas y programas de gestión y aseguramiento de la calidad, en empresas e instituciones, realizar investigación científica y tecnológica con difusión de sus resultados.
- Profesor: Margarita Martínez García
